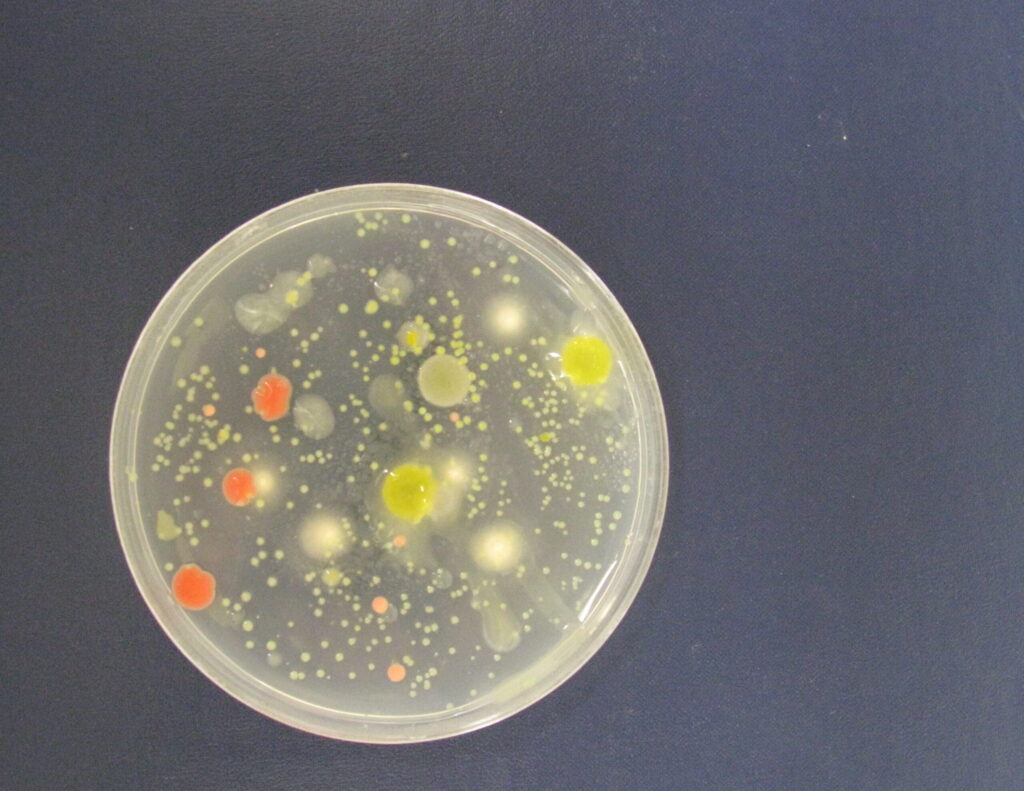
BioConsortia set to present at two separate events

Category: Sustainability
November Organic Grower Summit registration opens
Organic Grower Summit 2023 Organic Produce Network Western Growers technology
North Michigan Perennial Farm Ecosystem conference scheduled
Michigan Perennial Farm Ecosystem Conference Leelanau Conservation District perennial crops native beneficial habitat pollinators soil invertebrates soil health vegetation management sap analysis
Adapting to challenges
Henderson Farms values workers and employing environmental practices
Timac Agro releases homogeneous granular fertilizer
Timac Agro crop nutrition sustainability fertilizer soil nutrients crop nutrition Rainbow Plant Food
A change in philosophy
Terranova Ranch thrives by focusing on water, energy conservation
Syngenta Biologicals now handles Syngenta’s biologicals businesses
Syngenta Biologicals soil health crop protection biostimulants
Diesel ending worries California compost dealers
California diesel trucks compost sustainability climate transportation nuts
Salinas Biological Summit
Precision ag tools will help in the transition period as growers decrease pesticides
Balchem wins organic foliar registrations for tree nuts
Balchem Plant Nutrition receives registration for organic foliar products that can aid growers of organic tree nuts, fruit and vegetables.
California State Board of Food and Agriculture discusses statewide climate plan
The California State Board of Food and Agriculture will discuss opportunities for action related to Ag Vision for the Next Decade.
California’s project increases water supply allocation
The Department of Water Resources (DWR) announced another increase in the forecasted State Water Project (SWP) deliveries this year.
USDA invests in sustainable ag research, education
The U.S. Department of Agriculture announced an investment of more than $46 million in the Sustainable Agriculture Research program.
BioConsortia set to present at two separate events
BioConsortia announced its company leaders will highlight its team’s nitrogen- fixing microbial products in two separate events this spring.
The Organic Center and Foundation for Food & Agriculture Research provides $2.4 million in funding
The Organic Center and the Foundation for Food & Agriculture Research (FFAR) announced the provision of $2.4 million in funding.
USDA invests $75 Million in conservation assistance for producers
The U.S. Department of Agriculture (USDA) has invested $75 million in conservation assistance for producers transitioning to organic production.